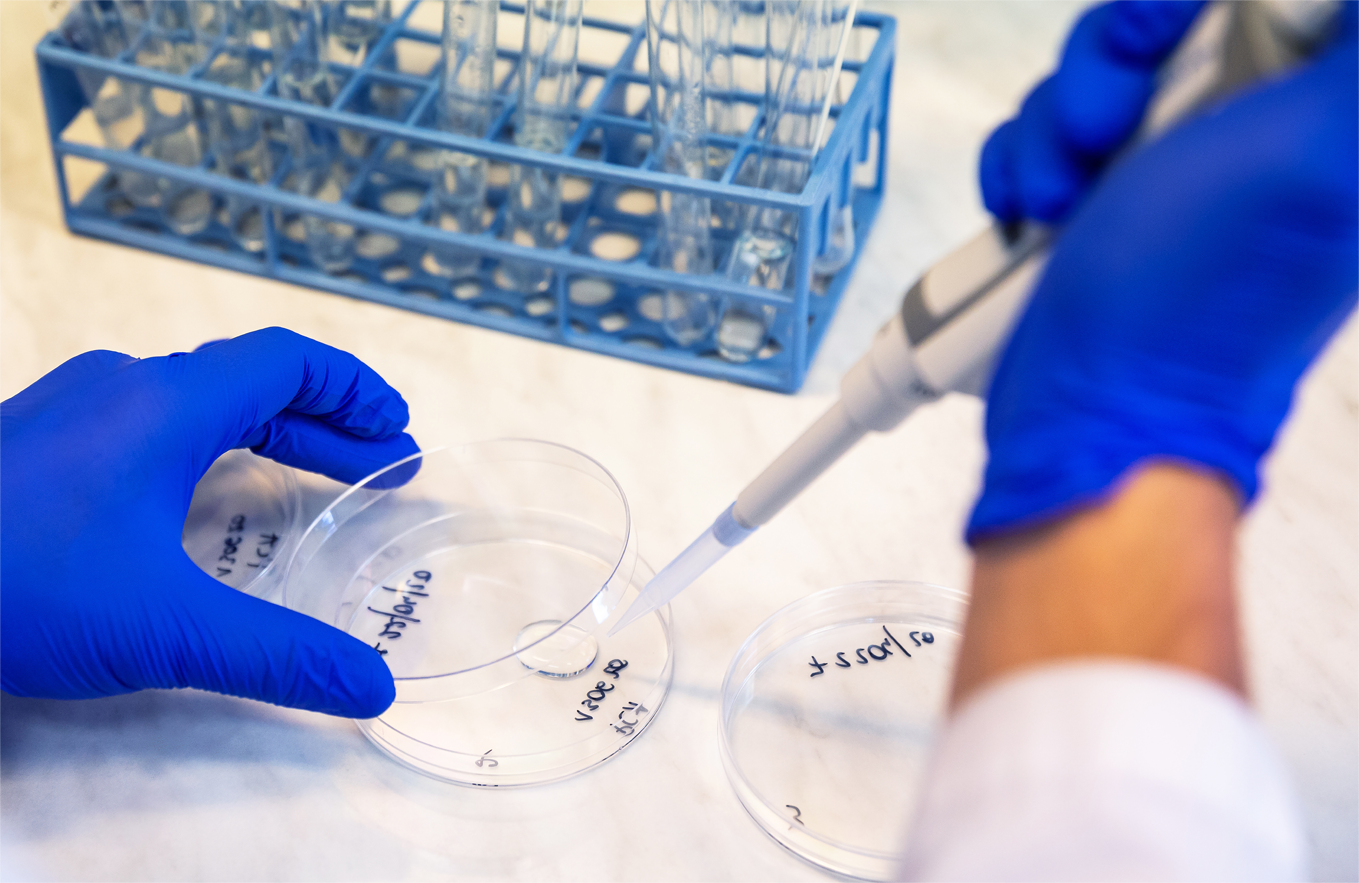

Efficacy You Can Trust.

Unsere Tests basieren auf dem Wissen und der langjährigen Erfahrung von Expertinnen und Experten, die die Wirksamkeit, Sicherheit und Qualität von Kosmetika sorgfältig prüfen.
Wir unterstützen die Entwicklung vieler Marken
















Einfacher Prozess der Zusammenarbeit:
Identifizieren Sie Ihren Bedarf
Finden Sie die Tests, die Sie für Ihr Produkt durchführen möchten.
Nehmen Sie Kontakt mit uns auf
Unter Vertriebsteam informiert Sie gerne über alle Details.
Prüfung beginnen
Bestellen Sie Tests und verfolgen Sie Ihre Fortschritte mit uns.
Einen Prüfbericht erhalten
Sie erhalten detaillierte Berichte, die die Wirksamkeit und Sicherheit Ihres Produkts bestätigen.
GBA GROUP
Profitieren Sie von unserem Fachwissen über Prüfungen an Standorten in der ganzen Welt

Experten-Ansatz
Überwachung durch Experten: Verlassen Sie sich auf ein großes Team von Spezialisten, einschließlich Dermatologen, Augenärzten, Gynäkologen, Kinderärzten und anderen, die eine strenge Überwachung aller Studien gewährleisten.
Flexibel, anpassungsfähig
Maßgeschneiderter Ansatz: Profitieren Sie von unserer globalen Reichweite in Kombination mit individuellen und flexiblen Lösungen, die auf jeden Kunden und jedes Projekt zugeschnitten sind und sicherstellen, dass Ihre spezifischen Anforderungen erfüllt werden.
Angebot an den Kunden

Qualität
Hochqualitative Strategien, zuverlässige und strenge Ergebnisse: Verlassen Sie sich auf Ergebnisse, die aus strengen Protokollen abgeleitet sind, die die Einhaltung klinischer Vorschriften, eine erhöhte Anzahl von Wiederholungen und eine gründliche statistische Analyse gewährleisten.

Innovation und Wissenschaft
Hochmoderne Technologie: Wir verwenden die neuesten Instrumente und Technologien sowohl bei In-vitro- als auch bei klinischen Studien, um genaue und zuverlässige Ergebnisse zu erzielen.
Was sagen unsere Kunden über die Zusammenarbeit mit uns?













